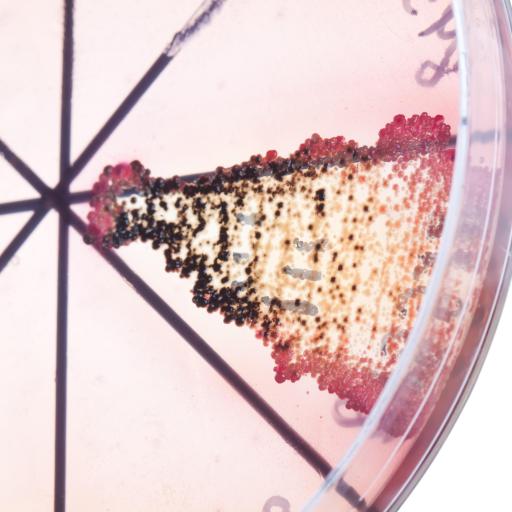

Search
Orion Jones
Managing Editor
Get smarter, faster, for success in the knowledge economy. Like us on https://t.co/6ZFWKpoKLi or visit https://t.co/d7r7dG2XOq
Read Less

Recent research on what motivates friendship in human and animals societies has challenged theories of evolutionary biology which suggest reciprocal bonds are formed simply to survive.

Scientists in the UK have sketched workable plans to encode hard data onto strands of human DNA which, instead of decaying like computers, would last three billion years or more.

"Being a submissive or dutiful patient doesn’t always pay off," says Susan Gubar, professor emerita of English at Indiana University. "Sometimes it's good to be bad."

Bioethicist Daniel Callahan has made a case for the public derision of people who overeat in a style similar to how smokers have been sent outside, taxed more and are generally stigmatized.

University of Wisconsin scientists have lifted a self-imposed moratorium on flu research, initially imposed for fear that information on flu mutations could fall into the wrong hands.
Biology labs are now inexpensive and mobile enough to be set up in a garage. The kind of genetic tinkering occurring across the nation mirrors the experiments in computing a generation earlier.

A debate is raging between economists: Some say the world has picked the low hanging fruit of innovation while others say a new era of unimaginable innovation is yet to come.

New research suggests that loneliness acts on the body similarly to physical stress by causing the inflammation of certain proteins associated with conditions like heart disease and Type 2 diabetes.

A study which followed 200 British medical patients diagnosed with depression found that the use of self-help books, coupled with counselling sessions on how to use the books, alleviated depression.

A new consumer study concludes that the happiness derived from anticipating a new purchase is often greater than the emotional benefits received from the material good itself.

Sadly, much of the passion and intimacy of new love is bound to fade. Still, there are concrete ways to maintain positive feelings and warmth in long-term relationships, say psychologists.

A new technique which asks patients to move their eyes rapidly while recalling past traumatic events successfully relieves symptoms of the disorder, but psychologists don't yet know how.

The development of cooking technology has both benefited our health and caused surprising physiological changes, such as prompting the emergence of the overbite, which all humans now have.

Because such a wealth of personal information on nearly everyone is now available online, a person's anonymous genetic information is enough to identify an individual's full name.

By making adult skin cells behave like a specific class of stem cells called pluripotent cells, scientists are looking to establish the field of regenerative medicine and test drugs in new ways.

The ability of food to affect all of our senses, and recent technological developments that have made cooking a more precise exercise, have caught the attention of the professional art world.

Some worry that the new American standard for mental illness diagnostics, the DSM-5, actively seeks to pathologize normal human behavior, making sanity as unachievable as being a supermodel.

Evolutionary psychology has proven a powerful theory in explaining behavioral differences between men and women in terms of natural selection, but challenges to the idea have emerged.

A theory of mind called compartmentalization argues that the brain is much like an iPhone, loaded with a host of apps to meet different needs. Not all the apps cooperate, however.

What distinguishes human life from animal life is our ability to search for meaning. Differing from happiness, meaning implies transcending the self while happiness implies its satisfaction.